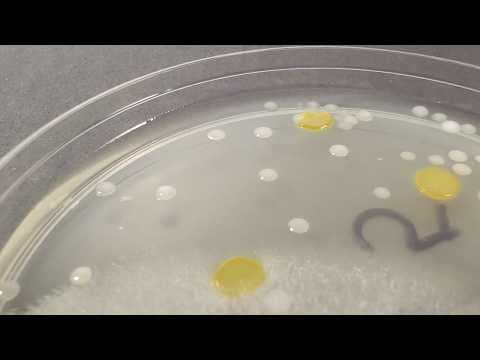
Can Bacteria Survive in Highly Acidic (or Basic) Water? | Science Project - YouTube

PSLE SCIENCE MADE SIMPLE EP89 | Fungi & Bacteria | Statements About Bacteria
By Owner - The Pique LabFrom youtube.com
726.5K views
53.9K likes
In this PSLE Science Made Simple episode, Ms. Cheryl will be analysing a 2017 Primary 3 Science examination question on the topic of Fungi & Bacteria from Maris Stella High School
Tags
Basic
education
bacteria
young
scientific
values
teens
teenagers
youth
moral
character
children
physics
kids
chemistry
biology
younsters
learn
teach
Concepts.scientist
fungi
discovery
science
build.personality
invention
Comments
Leave a Comment
Comments are loading... If you don't see any, be the first to comment!
Related Videos
Science Kids Bacteria
Owner-Powered by Boclips

Can Bacteria Survive Extreme Temperatures? | Science Project - YouTube
Science Buddies - YouTube

PSLE SCIENCE MADE SIMPLE EP109 | Plants, Fungi & Bacteria
Owner - The Pique Lab

Bacteria
Owner-National Digital Library of India

6 Amazing Science Facts about DNA, Bacteria, Dark Matter and More
Owner - Math and Science
Bacteria (Updated)
Amoeba Sisters

Bacteria Growth
ScienceKids
Cartoon for Kids‼️ Bacteria in the Gut. Science for Children
Gharbala Website

Can Bacteria Survive in Highly Acidic (or Basic) Water? | Science Project - YouTube
YouTube

PSLE SCIENCE MADE SIMPLE EP90 | Fungi & Bacteria | Slowing Down The Growth Of Mould
Owner - The Pique Lab